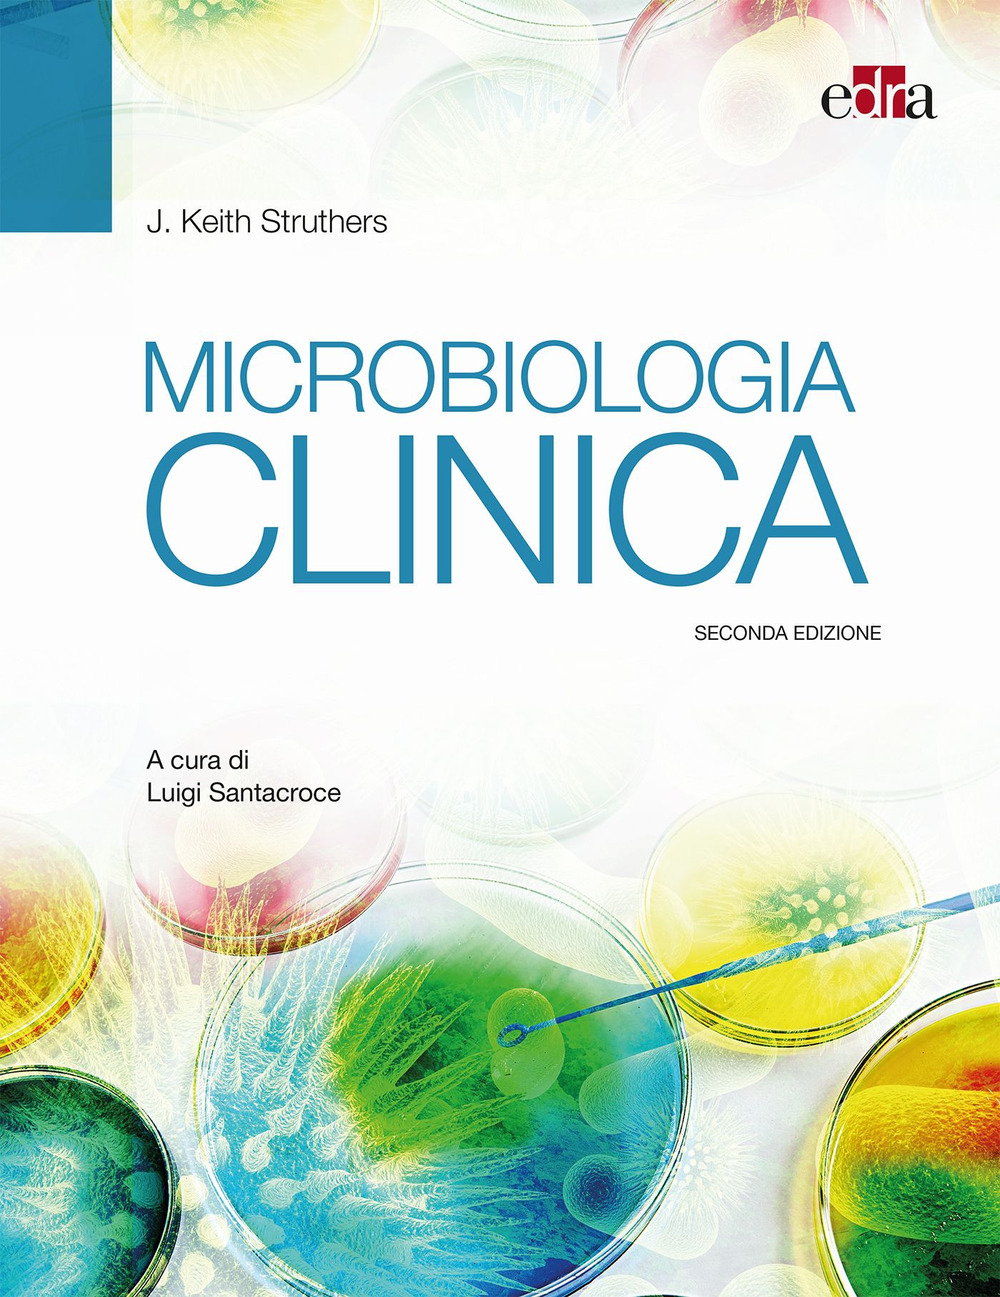
Microbiologia clinica

Editore
Edra
817 libri per questo editore.

Non disponibile
Crescita personale
Insegnare il programma autocompassione e mindfulness. Una guida per professionisti del benessere e della salute
39,00 €

Non disponibile
Medicina e professioni
Manuale di social skills training nell’intervento con persone con autismo in adolescenza ed età adulta
10,90 €

Non disponibile
Medicina e professioni
Anatomia radiologica di Weir & Abrahams. Atlante di anatomia umana per bioimmagini
42,00 €

Non disponibile
Medicina e professioni
Odontoiatra e paziente. Gli interventi odontoiatrici spiegati al paziente
49,00 €

Non disponibile
Medicina e professioni
Nelson&Fossum. Medicina interna e Chirurgia del cane e del gatto
239,00 €

Non disponibile
Società e antropologia
Uniche come me. Terapia cognitivo-comportamentale per ragazze nello spettro autistico
25,00 €

Non disponibile
Medicina e professioni
Nutrire l’immunità contro Covid-19. Integrare la cura cambiare la sanità
4,90 €

Non disponibile
Medicina e professioni
Adhesive cementation on natural teeth. Materials and techniques
99,00 €

Non disponibile
Società e antropologia
L'eredità di Freud. Percorsi di sviluppo in psicologia dinamica
20,00 €

Non disponibile
Società e antropologia
Disabilità intellettiva e disturbi dello spettro dell'autismo. Comportamenti problema, vissuti dei genitori, interventi assistiti con il cavallo
19,90 €

Non disponibile
Crescita personale
Mindfulness: psicologia buddhista e scienza. Le conoscenze essenziali per istruttori e terapeuti
29,00 €

Non disponibile
Medicina e professioni
Rugarli. Medicina interna sistematica. Estratto: Malattie del sistema endocrino e del metabolismo
22,90 €
Non disponibile
Medicina e professioni
Rugarli. Medicina interna sistematica. Estratto: Malattie dell'apparato digerente, del fegato e del pancreas
19,90 €